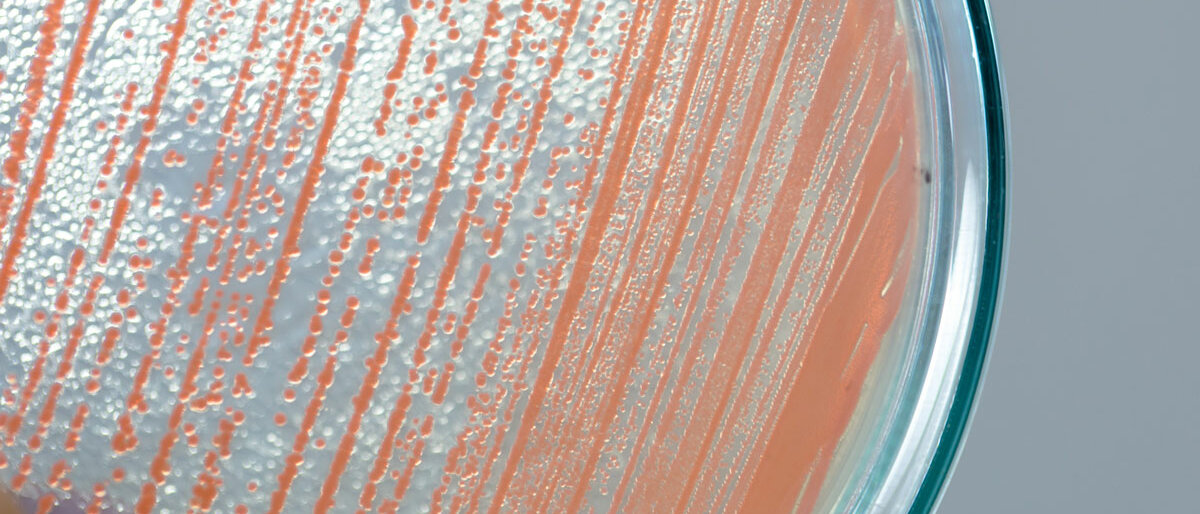

Entdeckung | Medizinforschung
VERURSACHT EIN BAKTERIUM VOLKSLEIDEN WIE ALZHEIMER UND DIABETES?
Seite 1/1 2 Minuten
Jede PTA kennt die Geschichte von Helicobacter pylori – bereits vor Jahrzehnten wies ein Wissenschaftler nach, dass Magengeschwüre weder psychisch bedingt noch aus ungesundem Essen entstehen – sondern dass schlicht ein Keim dafür verantwortlich ist, den man mit Antibiotika bekämpfen kann. Zahlreichen Menschen blieb danach die lebenslange Diät aus Haferschleim und Kamillentee erspart.
Bereits Anfang des Jahres wurde nachgewiesen, dass sich Porphyromonas gingivalis im Gehirn bereits Verstorbener, aber auch im Gehirnwasser lebender Alzheimer-Patienten fand. Und nun berichteten Wissenschaftler, dass sich das Stäbchen-Bakterium auch noch an anderen Stellen des Körpers aufhalten kann: in verengten Herzkrankgefäßen zum Beispiel oder in chronisch entzündeten Gelenken. Es soll auch für Darmkrebs, Diabetes, Herzkrankheiten und Lungenentzündungen mitverantwortlich sein.
Doch wo kommt das Bakterium eigentlich her? Die Mikrobe ist unter Zahnmedizinern bestens bekannt: Sie löst nämlich Parodontitis aus. Bei dieser Erkrankung entzünden sich Zahnfleisch, Zahnhalteapparat und später sogar die Kieferknochen, wenn sie nicht behandelt wird. In Deutschland sind immerhin 14 Prozent der 40-Jährigen und 40 Prozent der 70-Jährigen betroffen. Durch kleine Verletzungen können diese Keime beim Essen oder der Zahnreinigung ins Blut gelangen und so offenbar große Schäden anrichten.
Durch die Befunde alarmiert, infizierten die Forscher daraufhin die Mundhöhle von Mäusen mit dem Bakterium – und fanden sie wenig später in den Gehirnen der Tiere wieder, wo sie Beta-Amyloid-Ablagerungen gebildet hatten, die ja in Verbindung mit der Alzheimerschen Krankheit stehen.
Ist also Porphyromonas gingivalis auch für andere Erkrankungen verantwortlich, die oben genannt wurden und zu den Volksleiden gehören? Und könnte man eventuell durch ein neues Antibiotikum die Schäden, die es anrichtet, ebenso ausmerzen wie es die Antibiose gegen Helicobacter pylori geschafft hat? Dieser Frage geht eine US-Pharma-Firma nun nach: Sie testet ein Medikament, das einen Giftstoff von Porphyromonas blockiert. Andere amerikanische Forscher tüfteln an einer Impfung gegen das Bakterium. Die Immunologin Caroline Genco erklärte außerdem, dass es vielversprechende Versuche geben, die Keime mit einer Blaulicht-Therapie zu bekämpfen.
Professor Thomas Kocher, Direktor der Poliklinik für Zahnerhaltung, Parodontologie und Endodontologie an der Uni Greifwald, setzt bis dahin auf die kleine Lösung: Man solle einfach auf seine Mundhygiene achten. Dazu zähle vor allem die Reinigung der Zahnzwischenräume, wodurch die Keimzahl minimiert werde.
Alexandra Regner,
PTA und Journalistin
Quellen:
Die Welt
Focus online